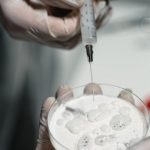
Buy THC vapes in Sintra image_48.jpg

Sintra, a picturesque town in Portugal known for its stunning palaces and castles, has seen a growing interest in THC vapes. As the demand for cannabis products continues to rise, understanding the options for THC vapes delivery in Sintra is essential for both residents and visitors.
Understanding THC Vapes
THC vapes, or tetrahydrocannabinol vaporizers, are devices that allow users to inhale the psychoactive compound found in cannabis; They offer a discreet and convenient way to consume THC, making them increasingly popular among cannabis enthusiasts.
Legal Considerations
In Portugal, cannabis laws have evolved significantly. While recreational cannabis remains illegal, medical cannabis is permitted, and certain cannabis products, including those containing CBD, are legal as long as they comply with specific regulations. THC vapes fall into a gray area and are subject to the country’s narcotics laws. It’s crucial to understand the legal landscape before purchasing or using THC vapes in Sintra.
Delivery Services
Several delivery services have emerged to cater to the demand for cannabis products in Sintra. These services vary in their offerings, pricing, and discretion. Some popular options include:
- Local Dispensaries: Some local dispensaries offer delivery services for cannabis products, including THC vapes. These establishments often have a wide range of products and knowledgeable staff.
- Online Retailers: Online retailers specializing in cannabis products may offer delivery to Sintra. It’s essential to verify the retailer’s legitimacy and compliance with Portuguese laws.
- Specialized Delivery Services: Companies focusing on cannabis delivery provide a convenient option for those seeking THC vapes. These services often prioritize discretion and customer service.
Things to Consider
When opting for THC vapes delivery in Sintra, several factors should be considered:
- Product Quality: Ensure that the products are of high quality and lab-tested.
- Legality: Understand the legal implications of purchasing and using THC vapes in Portugal.
- Discretion: Opt for services that prioritize discreet packaging and delivery.
- Customer Service: Choose retailers or delivery services with good customer reviews and support.
THC vapes delivery in Sintra offers a convenient option for those interested in cannabis products. By understanding the legal considerations, available delivery services, and factors to consider, individuals can make informed decisions. As with any cannabis product, it’s essential to use THC vapes responsibly and in compliance with local laws.
Benefits of THC Vapes
THC vapes have gained popularity due to their potential benefits, including:
- Ease of Use: Vaping THC is often considered more straightforward than smoking cannabis, as it eliminates the need to roll joints or pack pipes.
- Discretion: THC vapes are generally more discreet than smoking, making them a preferred choice for those who value privacy.
- Controlled Dosage: Vaping allows users to control their THC intake more accurately, as they can take smaller puffs and monitor their effects.
- Potential Health Benefits: Some users report that vaping THC is less harsh on the lungs compared to smoking, although the long-term health effects are still being studied.
Choosing the Right THC Vape
With numerous options available, selecting the right THC vape can be challenging. Consider the following factors:
- Device Type: THC vapes come in various forms, including disposable pens, refillable cartridges, and mods. Each type offers different levels of convenience and customization.
- THC Concentration: THC vapes are available in different concentrations. Beginners may prefer lower concentrations, while experienced users may opt for higher potency products.
- Flavor and Terpene Profile: The flavor and terpene profile can significantly impact the vaping experience. Some users prefer products with specific terpenes for their potential effects and flavors.
Safe Consumption Practices
To ensure a safe and enjoyable experience with THC vapes, follow these guidelines:
- Start Low and Go Slow: Begin with a low dose and gradually increase as needed to avoid adverse effects.
- Stay Hydrated: Vaping can cause dry mouth, so it’s essential to stay hydrated by drinking plenty of water.
- Be Aware of Your Surroundings: Consume THC vapes in a comfortable and safe environment, especially if you’re new to vaping.
Future Outlook
As the cannabis industry continues to evolve, the demand for THC vapes is likely to grow. Advances in technology and increasing legalization may lead to more innovative products and safer consumption methods. Staying informed about the latest developments and regulations will be crucial for those interested in THC vapes in Sintra.
Regulations and Compliance
As the cannabis industry expands, regulatory bodies are continually updating laws and guidelines. In Portugal, the Autoridade Nacional do Medicamento e Produtos de Saúde (INFARMED) oversees the regulation of cannabis and cannabis-related products. Ensuring compliance with these regulations is crucial for both retailers and consumers.
Key Regulatory Considerations
- Product Testing: THC vapes must undergo rigorous testing to ensure they meet safety and quality standards.
- Labeling and Packaging: Products must be labeled accurately, including information on THC content, ingredients, and potential health risks.
- Age Restrictions: Sales of THC vapes are restricted to adults, typically those over 18 or 21 years old, depending on local laws.
Education and Awareness
As THC vapes become more prevalent, education and awareness are vital to promoting responsible use. Consumers should be informed about the potential benefits and risks associated with THC vapes, including:
- Dependence and Addiction: THC vapes can be habit-forming, and frequent use may lead to dependence.
- Health Risks: Vaping has been linked to various health concerns, including respiratory issues and nicotine poisoning.
- Interactions with Other Substances: THC can interact with other medications and substances, potentially leading to adverse effects.
Resources for Consumers
Several organizations and resources are available to provide information and support for those using THC vapes:
- Health Professionals: Consulting with a healthcare professional can provide personalized advice on using THC vapes.
- Online Resources: Reputable websites and forums offer information on THC vapes, including product reviews and safety guidelines.
- Support Groups: Joining a support group can be beneficial for those struggling with cannabis use or dependence.
The landscape of THC vapes delivery in Sintra is evolving, driven by growing demand and advances in technology. By staying informed about regulations, product quality, and safe consumption practices, consumers can make the most of this emerging market. As the industry continues to mature, prioritizing education and awareness will be essential for promoting responsible use and minimizing potential risks.
2 thoughts on “THC vapes delivery in Sintra”
Leave a Reply Cancel reply
You must be logged in to post a comment.

The article provides a comprehensive overview of the THC vapes delivery options in Sintra, Portugal, which is very informative for both residents and tourists.
I appreciate the detailed explanation of the legal considerations surrounding THC vapes in Portugal, it highlights the importance of understanding local laws before making a purchase.